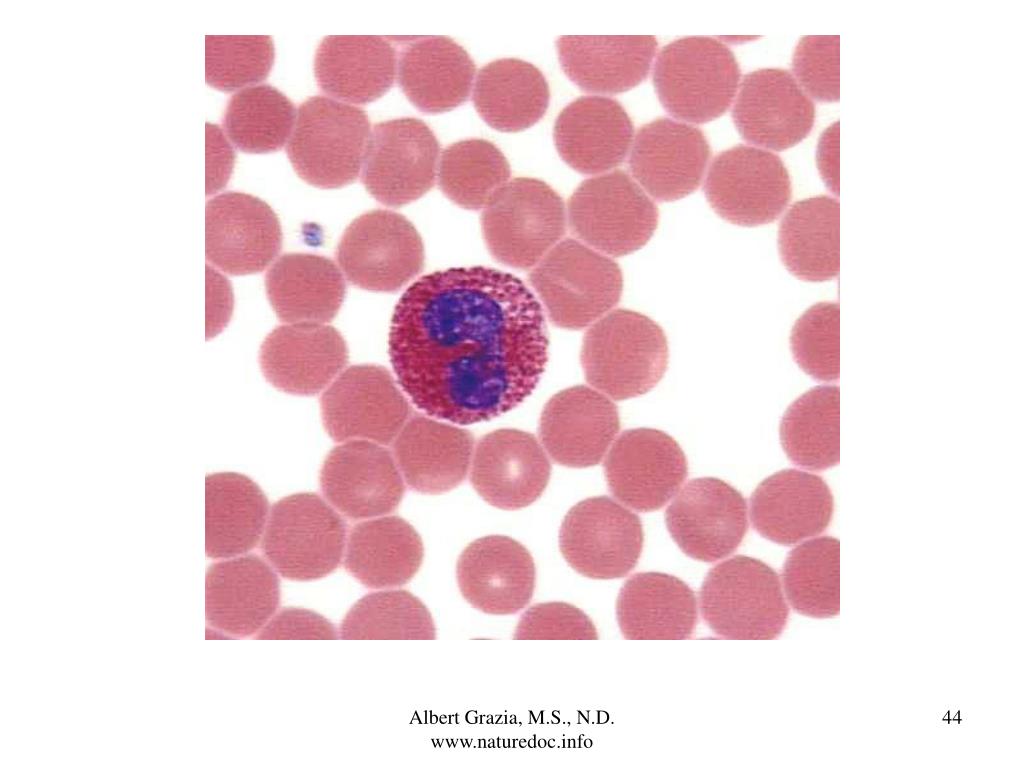

Эозинофилы цвет
Эозинофилы цвет 108 фотографий
Соответствие навыка и группы
Iphone авторизация
Желаю крепкого здоровья надежных друзей
Полынь и амброзия
Gaming mode mod
Годжо сатору арт 18
Лев большой театр
Mustang gt 2015
Pleasure betcha
Хонор выключился и не включается что делать
Жарка горячим воздухом
Тест драйв форд 2
Банк просит придти
Мученица 5
Производитель пластиковых профилей
Каналы звука в наушниках
Fundcrafters
Ниссан санни замена прокладки
Служба внутреннего контроля статья
Школа 94 ростов на дону адрес